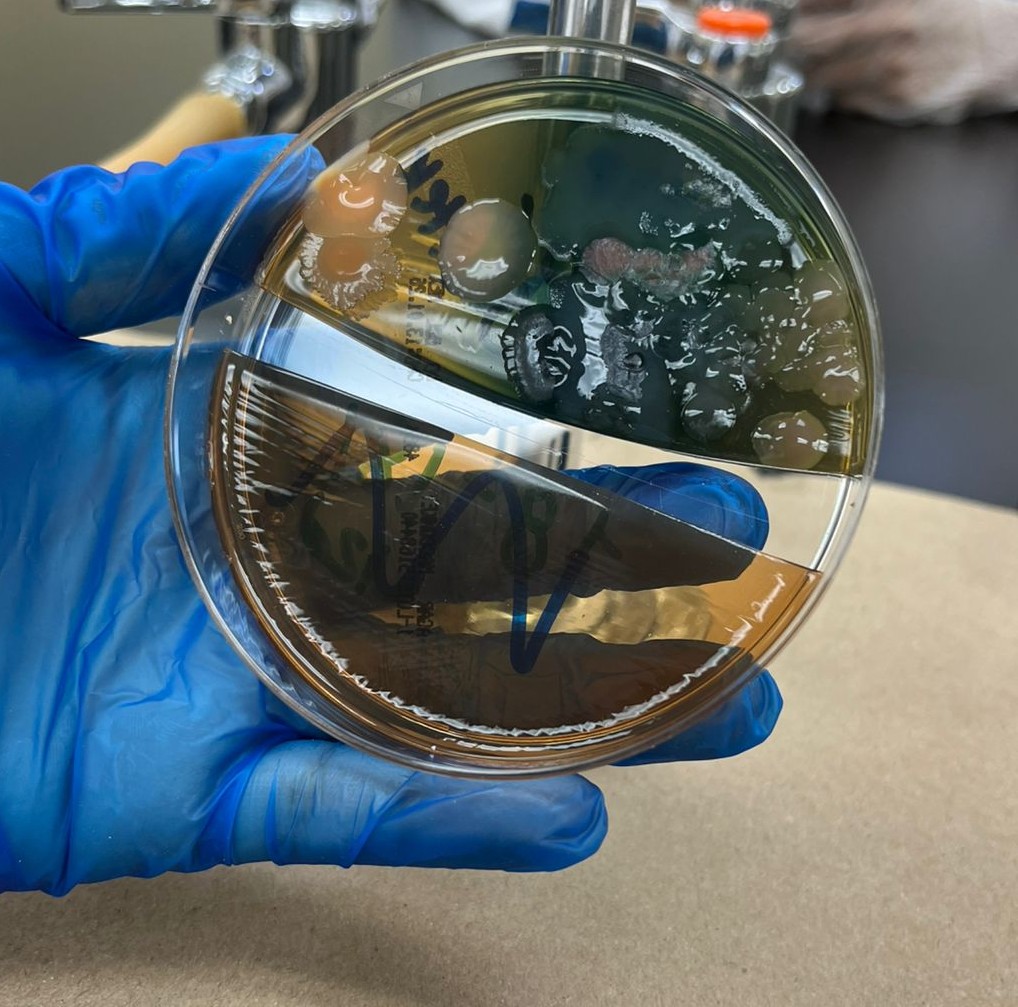

Hello World
Hello my name is Dennis. I like to draw, listen to music and play roblox. I'm also making a comic titled "The Dollhouse". I will post my art and a little bit of my life in this section.
Whatisgraphicdesign.com
 Awesome gayming moments
Awesome gayming moments
First me update [05.10.25]
I kinda suck at this html stuff, but I like it. Here's some doodles I've made the past month + my daily life.
Stupid June & kibble


Meowsome MacConkey agar and some gaggles

John :) #yeah

Ououghough [12.10.25]
idc idc idc..... KILL THEM!!!!!!!!!


Various Screenshots [07.01.26]
Not much going on. My winter break is almost over.






